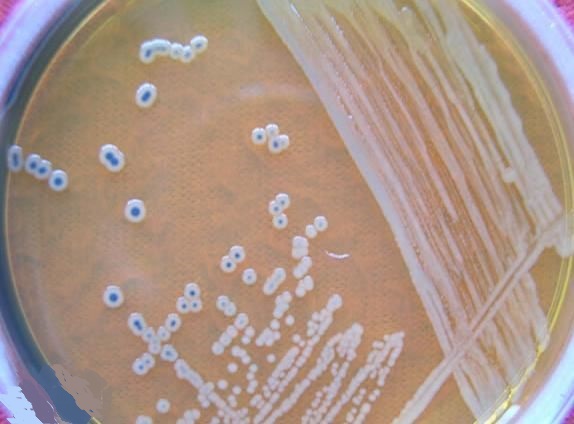

计量员证书 內校员资格证 计量管理员培训 计量校准员考证 计量检定员考试 计量检测员报名 量规仪器校正员培训 内部校验员合格证 内部校准员上岗证 计量内审员岗位证 仪校员证书 计量工资质 计量师资格证书 计量证怎么考 內校证书哪里考 农产品食品检验员资格证 食品化验员证书 食品检验工培训 食品检测员考证 化学检验员培训 水质检测员考试 化妆品检验员报名 微生物检验员证书 化验员上岗证 微检员证书 医疗器械检验员资质 化学分析工考证 环境监测员资格证
常见微生物培养基介绍
培养基是人工地将多种物质按各种微生物生长的需要配制而成的一种混合营养基质,用以培养或分离各种微生物。因此,营养基质应当有微生物所能利用的营养成分(包括碳源、氮源、能源、无机盐、生长因素)和水。根据微生物的种类和实验目的不同,培养基也有不同的种类和配制方法。
以下介绍一些实验中比较常见的培养基:
营养琼脂培养基:
营养琼脂培养基是用来进行普通细菌的繁殖培养,供细菌总数测定、保存菌种及纯培养用。主要成分为:牛肉浸出物、酵母抽提物、蛋白胨、氯化钠、琼脂粉、蒸馏水。蛋白胨和牛肉粉提供氮源、维生素、氨基酸和碳源,氯化钠能维持均衡的渗透压,琼脂是培养基的凝固剂。
营养琼脂为最基础的一类培养基,包含了大部分微生物生长所需要的营养物质,在进行常规的细菌培养时可以使用营养琼脂。

血琼脂培养基:
血琼脂培养基是一种含有脱纤维动物血(一般用兔血或羊血)的牛肉膏蛋白胨培养基,因此除培养细菌所需要的各种营养外,还能提供辅酶(如V因子),血红素(X因子)等特殊生长因子。因此血液培养基常用于培养,分离和保存对营养要求苛刻的某些病原微生物。
另外,血琼脂通常还用来进行溶血试验。一些细菌在生长过程中,可以产生溶血素,使红细胞破裂溶解,在血平板上生长时,菌落周围可观察到透明或半透明的溶血环,许多细菌的致病性都与溶血特性相关。由于不同细菌产生的溶血素不同,溶血能力也不相同,在血平板上的溶血现象也不相同,因此,溶血试验常用来进行细菌的鉴定。

TCBS培养基:
TCBS即硫代硫酸盐柠檬酸盐胆盐蔗糖琼脂培养基。用于致病性弧菌的选择性分离。蛋白胨、酵母浸粉在培养基中作为基础营养物质提供菌体生长所需的氮源、碳源及维生素等各种生长因子;较高浓度的氯化钠满足弧菌嗜盐生长的需要;蔗糖作为可发酵碳源;枸橼酸钠、高pH 碱性环境及硫代硫酸钠的存在抑制肠道菌的生长,牛胆粉、牛胆酸钠主要抑制革兰氏阳性菌的生长,此外,硫代硫酸钠还提供硫源,在柠檬酸铁存在的条件下可以检测细菌产硫化氢,如果有产硫化氢的细菌,则会在平板上生成黑色沉淀;TCBS培养基指示剂是溴甲酚蓝和和百里酚蓝,这两个化合物是酸碱指示剂。溴甲酚蓝是酸碱指示剂,pH变色范围3.8(黄色)~5.4(蓝绿色)。有两种变色范围:(1)酸范围为pH1.2~2.8,由黄色变红色;(2)碱范围为pH值8.0~9.6,由黄变蓝色。

TSA胰酪大豆胨琼脂培养基:
TSA成分与营养琼脂大致类似。在国标中通常用来做医药工业洁净室(区)沉降菌的测试。在待测区域内选取测试点,将TSA平板打开,布置在测试点。在空气中暴露30min以上不等时间进行采样,然后培养进行菌落计数。不同的洁净度等级要求不同的菌落数。

Mueller-Hinton琼脂:
M-H培养基是应用于检测微生物对于抗生素抗性的微生物培养基。它是一种无选择性培养基,大部分的微生物都可在上面生长。此外,成分中的淀粉可以吸收细菌所释放出来的毒素,因此不会影响抗生素操作的结果。M-H培养基的成分较为疏松,利于抗生素的扩散,使其可以显现明显的生长抑制带。在中国卫生行业中,也使用M-H培养基进行药敏试验。在对一些特殊细菌进行药敏试验时,例如肺炎链球菌,可能会在该培养基内添加5%的绵羊血及NAD以满足不同的营养需求。

SS琼脂:
SS琼脂通常用来做沙门氏菌,志贺氏菌的选择性分离培养。抑制革兰氏阳性菌及大多数的大肠菌群和变形杆菌,但不影响沙门氏菌的生长;硫代硫酸钠和枸橼酸铁用于检测硫化氢的产生,使菌落中心呈黑色;中性红为pH 指示剂,发酵糖产酸的菌落呈红色,不发酵糖的菌落为无色。沙门氏菌呈无色透明菌落有或无黑色中心,志贺氏菌呈无色透明菌落。
麦康凯琼脂培养基:
麦康凯琼脂培养基简称MAC培养基。主要成分为蛋白胨、脙胨、猪胆盐(或牛、羊胆盐) 氯化钠、琼脂、乳糖、1%结晶紫水溶液、0.5%中性红水溶液。MAC为一种选择性培养基,用于粪便、分泌物中肠道致病菌及肠球菌的分离培养。其原理是:胆盐可以抑制革兰氏阳性菌的生长,对伤寒等沙门菌的生长有促进作用。中性红可以把能分解乳糖和不分解乳糖的细菌区分开,呈现不同颜色。沙门菌及志贺菌呈无色菌落,大肠埃希菌呈桃红色菌落。不过麦康凯琼脂为一种弱选择性的培养基,一些其他的细菌也能在上面生长。

伊红美蓝琼脂培养基:
伊红美蓝琼脂培养基是一种弱选择性培养基,主要用于分离肠道病原菌,特别是大肠杆菌和粪大肠杆菌群。主要成分包含蛋白胨、乳糖、磷酸氢二钾、伊红、美蓝、琼脂。其原理是:伊红和美蓝为酸碱指示剂,伊红是酸性染料,美蓝是碱性染料。如果细菌分解乳糖产生酸时,细菌带有正电,与酸性染料结合,染上伊红的颜色;如果细菌产碱性物质则带负电,与碱性染料美蓝结合呈现蓝色。细菌产酸量较大时,染料可析出结晶形成黑色金属光泽菌落。

LB琼脂培养基:
LB琼脂培养基为一种实验室中广泛使用的普通培养基。主要成分为胰蛋白胨、酵母浸粉、琼脂、氯化钠。LB培养基通常用来培养基因工程受体菌(大肠杆菌),这类菌通常是经过改造无法在外界环境单独存活和扩增的工程菌。培养这类工程菌,我们可以表达大量的外源蛋白。因此LB培养基通常在基因工程、分子生物学中使用比较多。

R2A琼脂培养基:
在进行菌落计数的时候,通常使用PCA平板计数琼脂。但是对饮用水中的菌落数进行测定时候,通常使用R2A培养基。这是因为,饮用水通常使用含氯成分进行消毒,R2A培养基可以鞋服呗滤器损伤的细菌,支持耐氯细菌恢复生长;另一方面,R2A为一种低营养培养基,这使得这类细菌不会被快速生长的微生物覆盖,R2A培养时间较普通培养基更长,通常为2天以上,延长培养时间让微生物得到更好的恢复,提升回收率。若用其他普通计数平板进行培养计数,饮用水中的菌落总数通常是偏低的。

巧克力琼脂培养基:
巧克力琼脂培养基主要是用于奈瑟氏菌属和嗜血杆菌等需氧菌的分离和培养。主要是蛋白胨和牛肉粉用来提供细菌生长所需的碳源、氮源氨基酸以及维生素。氯化钠维持培养基中的渗透压,琼脂用做凝固剂。脱纤维羊血提供氯化血红素和辅酶I,为嗜血杆菌属的生长提供特殊营养。巧克力琼脂培养基还可以培养其他细菌,轻微进行加热将培养基中的红细胞破坏,释放出其中的V和X因子,细菌可对其进行利用。

BHI琼脂培养基:
BHI琼脂培养基又叫脑心浸液培养基。是非选择性培养基,广泛用于霉菌、酵母、细菌的培养。因为其营养成分丰富,所以通常用来做各种苛养型菌的培养,在普通培养基中不会生长的一些细菌,可在BHI中生长。BHI培养基可以支持各类致病菌生长,所以通常用来作致病细菌的分离和增菌。


